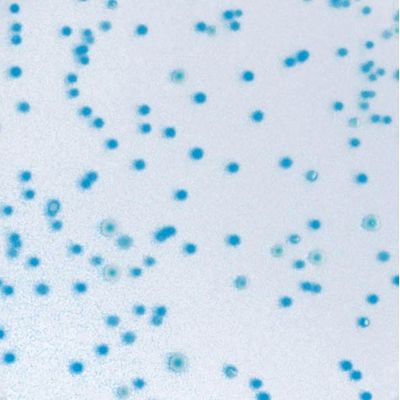

CHROMagar
CHROMagar - E.coli
FromCHROMagar
Performance: Contamination by faecal material from animals can be shown by the detection of Escherichia coli in the sample. E. coli can contaminate drinking water when the water treatment system is inadequate or during periods of very high rainfalls. Monitoring of food and water production is essential. High contamination may lead to the suspension of the water supply or food recall by supermarkets. Concerning bathing water, regulations are more and more strict: • European directive from 1976: 2.000 Escherichia coli (E. coli) bacteria for 100 mL of water. • New directive in 2006: 500 E. coli per 100 mL. The presence of E. coli indicates faecal contamination and potential presence of dangerous pathogens such as bacteria like Vibrio cholerae, Salmonella, Pseudomonas etc…, or viruses and intestinal parasites.
Most popular related searches
E. Coli
water treatment system
bathing water regulations
drinking water treatment system
fecal contamination
drinking water
E. Coli contamination
bathing water
membrane filtration
water regulations
The infections resulting from ingestion of contaminated matter can be dangerous and life-threatening.
- 24 h detection
- Easy reading and interpretation: The general food and water standards limits are usually from zero to single figure E. coli CFU per gram and thus it is important to detect and enumerate them accurately. With CHROMagar™ E. coli, colonies of E. coli develop with an intense blue colour, thus making detection and enumeration of this important hygiene indicator as simple as possible.
- Lighter workload: Traditional E. coli detection methods are extremely tedious and labor-intensive, requiring studies of many colonies.
- Quality: CHROMagar™ E.coli media contain 5 % more agar than other media on the market. This helps considerably with the application and streaking of the sample onto the plate. The media is also suitable for the membrane filtration technique or the pouring technique.
